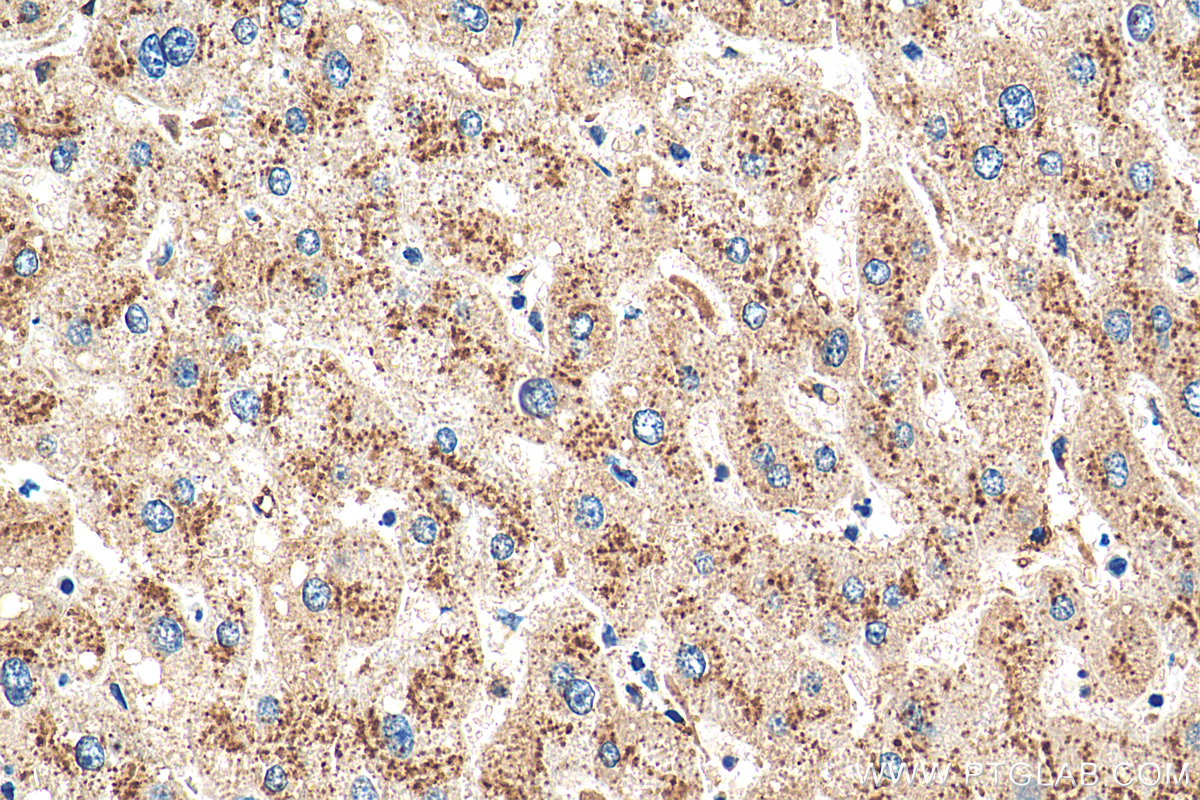

验证数据展示
产品信息
55021-1-PBS targets Cathepsin D in WB, IHC, Indirect ELISA applications and shows reactivity with human, mouse samples.
| 经测试应用 | WB, IHC, Indirect ELISA Application Description |
| 经测试反应性 | human, mouse |
| 免疫原 | Peptide 种属同源性预测 |
| 宿主/亚型 | Rabbit / IgG |
| 抗体类别 | Polyclonal |
| 产品类型 | Antibody |
| 全称 | cathepsin D |
| 别名 | |
| 计算分子量 | 45 kDa |
| 观测分子量 | 32 kDa |
| GenBank蛋白编号 | NM_001909 |
| 基因名称 | Cathepsin D |
| Gene ID (NCBI) | 1509 |
| RRID | AB_10863128 |
| 偶联类型 | Unconjugated |
| 形式 | Liquid |
| 纯化方式 | Antigen affinity purification |
| UNIPROT ID | P07339 |
| 储存缓冲液 | PBS only, pH 7.3. |
| 储存条件 | Store at -80°C. The product is shipped with ice packs. Upon receipt, store it immediately at -80°C |
背景介绍
CTSD (Cathepsin D) is also named as CPSD, belongs to the peptidase A1 family. It is ubiquitously expressed and is involved in proteolytic degradation, cell invasion, and apoptosis. Human CTSD is synthesized as a 52-kDa precursor that is converted into an active 48-kDa single-chain intermediate in the endosomes, and then into a fully active mature form, composed of a 34-kDa heavy chain and a 14-kDa light chain, in the lysosomes. It is a lysosomal acid protease found in neutrophils and monocytes and involved in the pathogenesis of several diseases such as breast cancer and possibly Alzheimer disease. (PMID: 27114232, PMID: 30717773, PMID: 30051532)